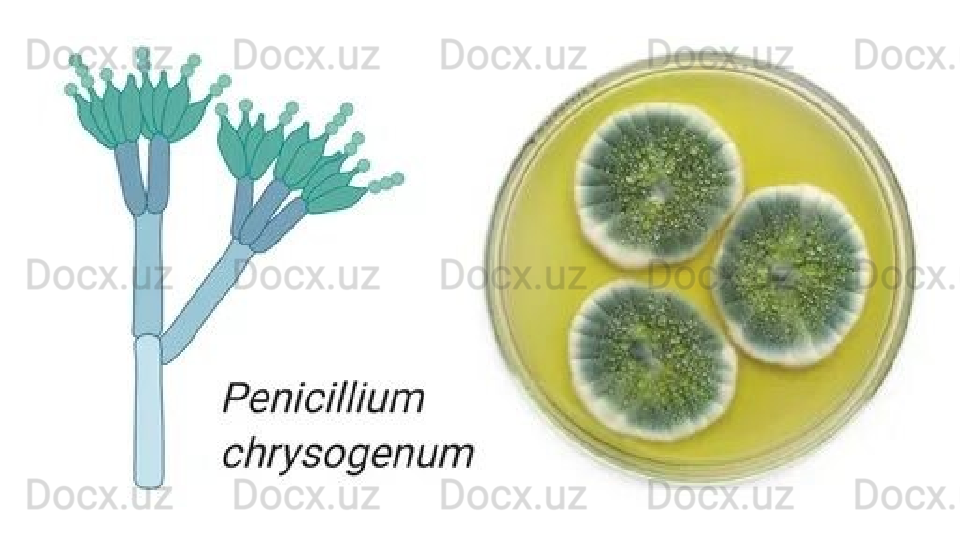

Дата регистрации 10 Май 2023
5700 ПродажMikroorganizmlardan antibiotiklar olish

Mikroorganizmlardan antibiotiklar olish